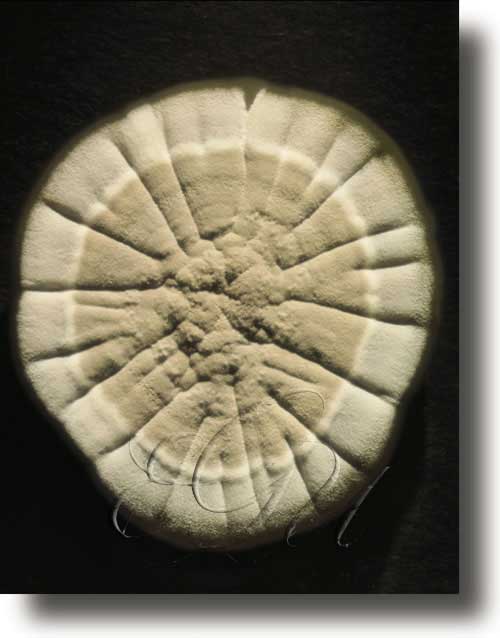

estreptomiceto -ta
(
-
adx
Relativo ou pertencente aos estreptomicetos.
-
s
m
[FUNGO]
Fungo da orde dos estreptomicetos.
-
s
m pl
[FUNGO]
Orde de fungos coloniais de micelio constituído por hifas de ramificación de tipo monopodial, de 1µ de espesor, non segmentadas e ocas. As hifas aéreas teñen a capacidade de orixinar conidios. Os estreptomicetos teñen unha grande importancia ecolóxica nos solos e son os responsables do típico cheiro da terra húmida. Para o home teñen importancia industrial como fonte de metabolitos secundarios, entre os que destacan máis de 500 substancias antibióticas distintas, como a aureomicina, obtida de Streptomyces aureofaciens, activa contra as bacterias da tuberculose, da difteria, e contra neumococos e gonococos, ou a cloromicetina, producida por Streptomyces venezuelae, activa contra algúns virus, rickettsias e bacterias Gram-negativas.